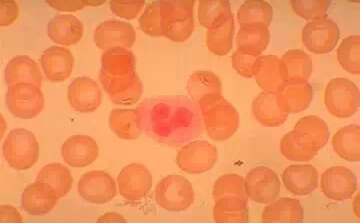

日本发现一种白血病癌细胞增殖机制
2015-07-29来源:厚朴方舟
据媒体报道,日本研究人员前沿研究发现了一种白血病癌细胞的增殖机制,并找到了抑制其增殖的方法,这一发现将有助开发治疗白血病等癌症的药物。
东京理科大学的研究人员对白血病中的肥大细胞白血病进行了研究,这种白血病是因肥大细胞在体内恶性增殖导致的。肥大细胞是一种免疫细胞,在肌体抗击过敏和发炎中发挥着至关重要的作用。
研究发现,一种位于肥大细胞表面的蛋白质“Kit”本来只在必要时才会促进细胞增殖,但其集中到细胞内部后就会持续发挥作用,由此导致肥大细胞不断恶性增殖。研究人员用药物阻止这种蛋白质聚集到肥大细胞内部后,发现肥大细胞也停止了恶性增殖。这一发现将有助探寻治疗白血病、肺癌和消化道癌等癌症的方法。
研究小组在人类细胞和大鼠细胞上发现了同样的机制,他们希望在这一研究基础上开发治疗药物,争取5年后投入实用。
厚朴方舟2012年进入海外医疗领域,总部位于北京,建立了由全球权威医学专家组成的美日名医集团,初个拥有日本政府官方颁发的海外医疗资格的企业。如果您有海外就医的需要,请拨打免费热线400-086-8008进行咨询!
本文由厚朴方舟编译,版权归厚朴方舟所有,转载或引用本网版权所有之内容须注明"转自厚朴方舟官网(www.hopenoah.com)"字样,对不遵守本声明或其他违法、恶意使用本网内容者,本网保留追究其法律责任的权利。
上一篇:没有了 下一篇:美国白血病男子注射艾滋病毒后癌细胞被清除
厚朴方舟
厚朴方舟出国看病机构是中国企业初个拥有日本政府颁发的国际医疗从业资格证的公司,多年来整合了全球权威医疗资源,一直致力于打造“以患者为中心”的专业就医服务平台。公司在北京,上海,日本,美国均有分公司,为客户提供一站式海外就医服务。
相关服务介绍

精密体检
日本医疗体检综合服务平台高性价比的专业体检套餐


远程会诊
足不出户与国际医学专家沟通新型用药方案和治疗方案


海外就医
专业的一站式海外就医服务国外专家预约、落地安排

咨询热线:400-086-8008
互联网药品信息服务资格证书编号:
(京)·非经营性·2015·0179
厚朴方舟健康管理(北京)有限公司 版权所有 www.hopenoah.com
京ICP备15061794号 京公网安备 11010502027115号